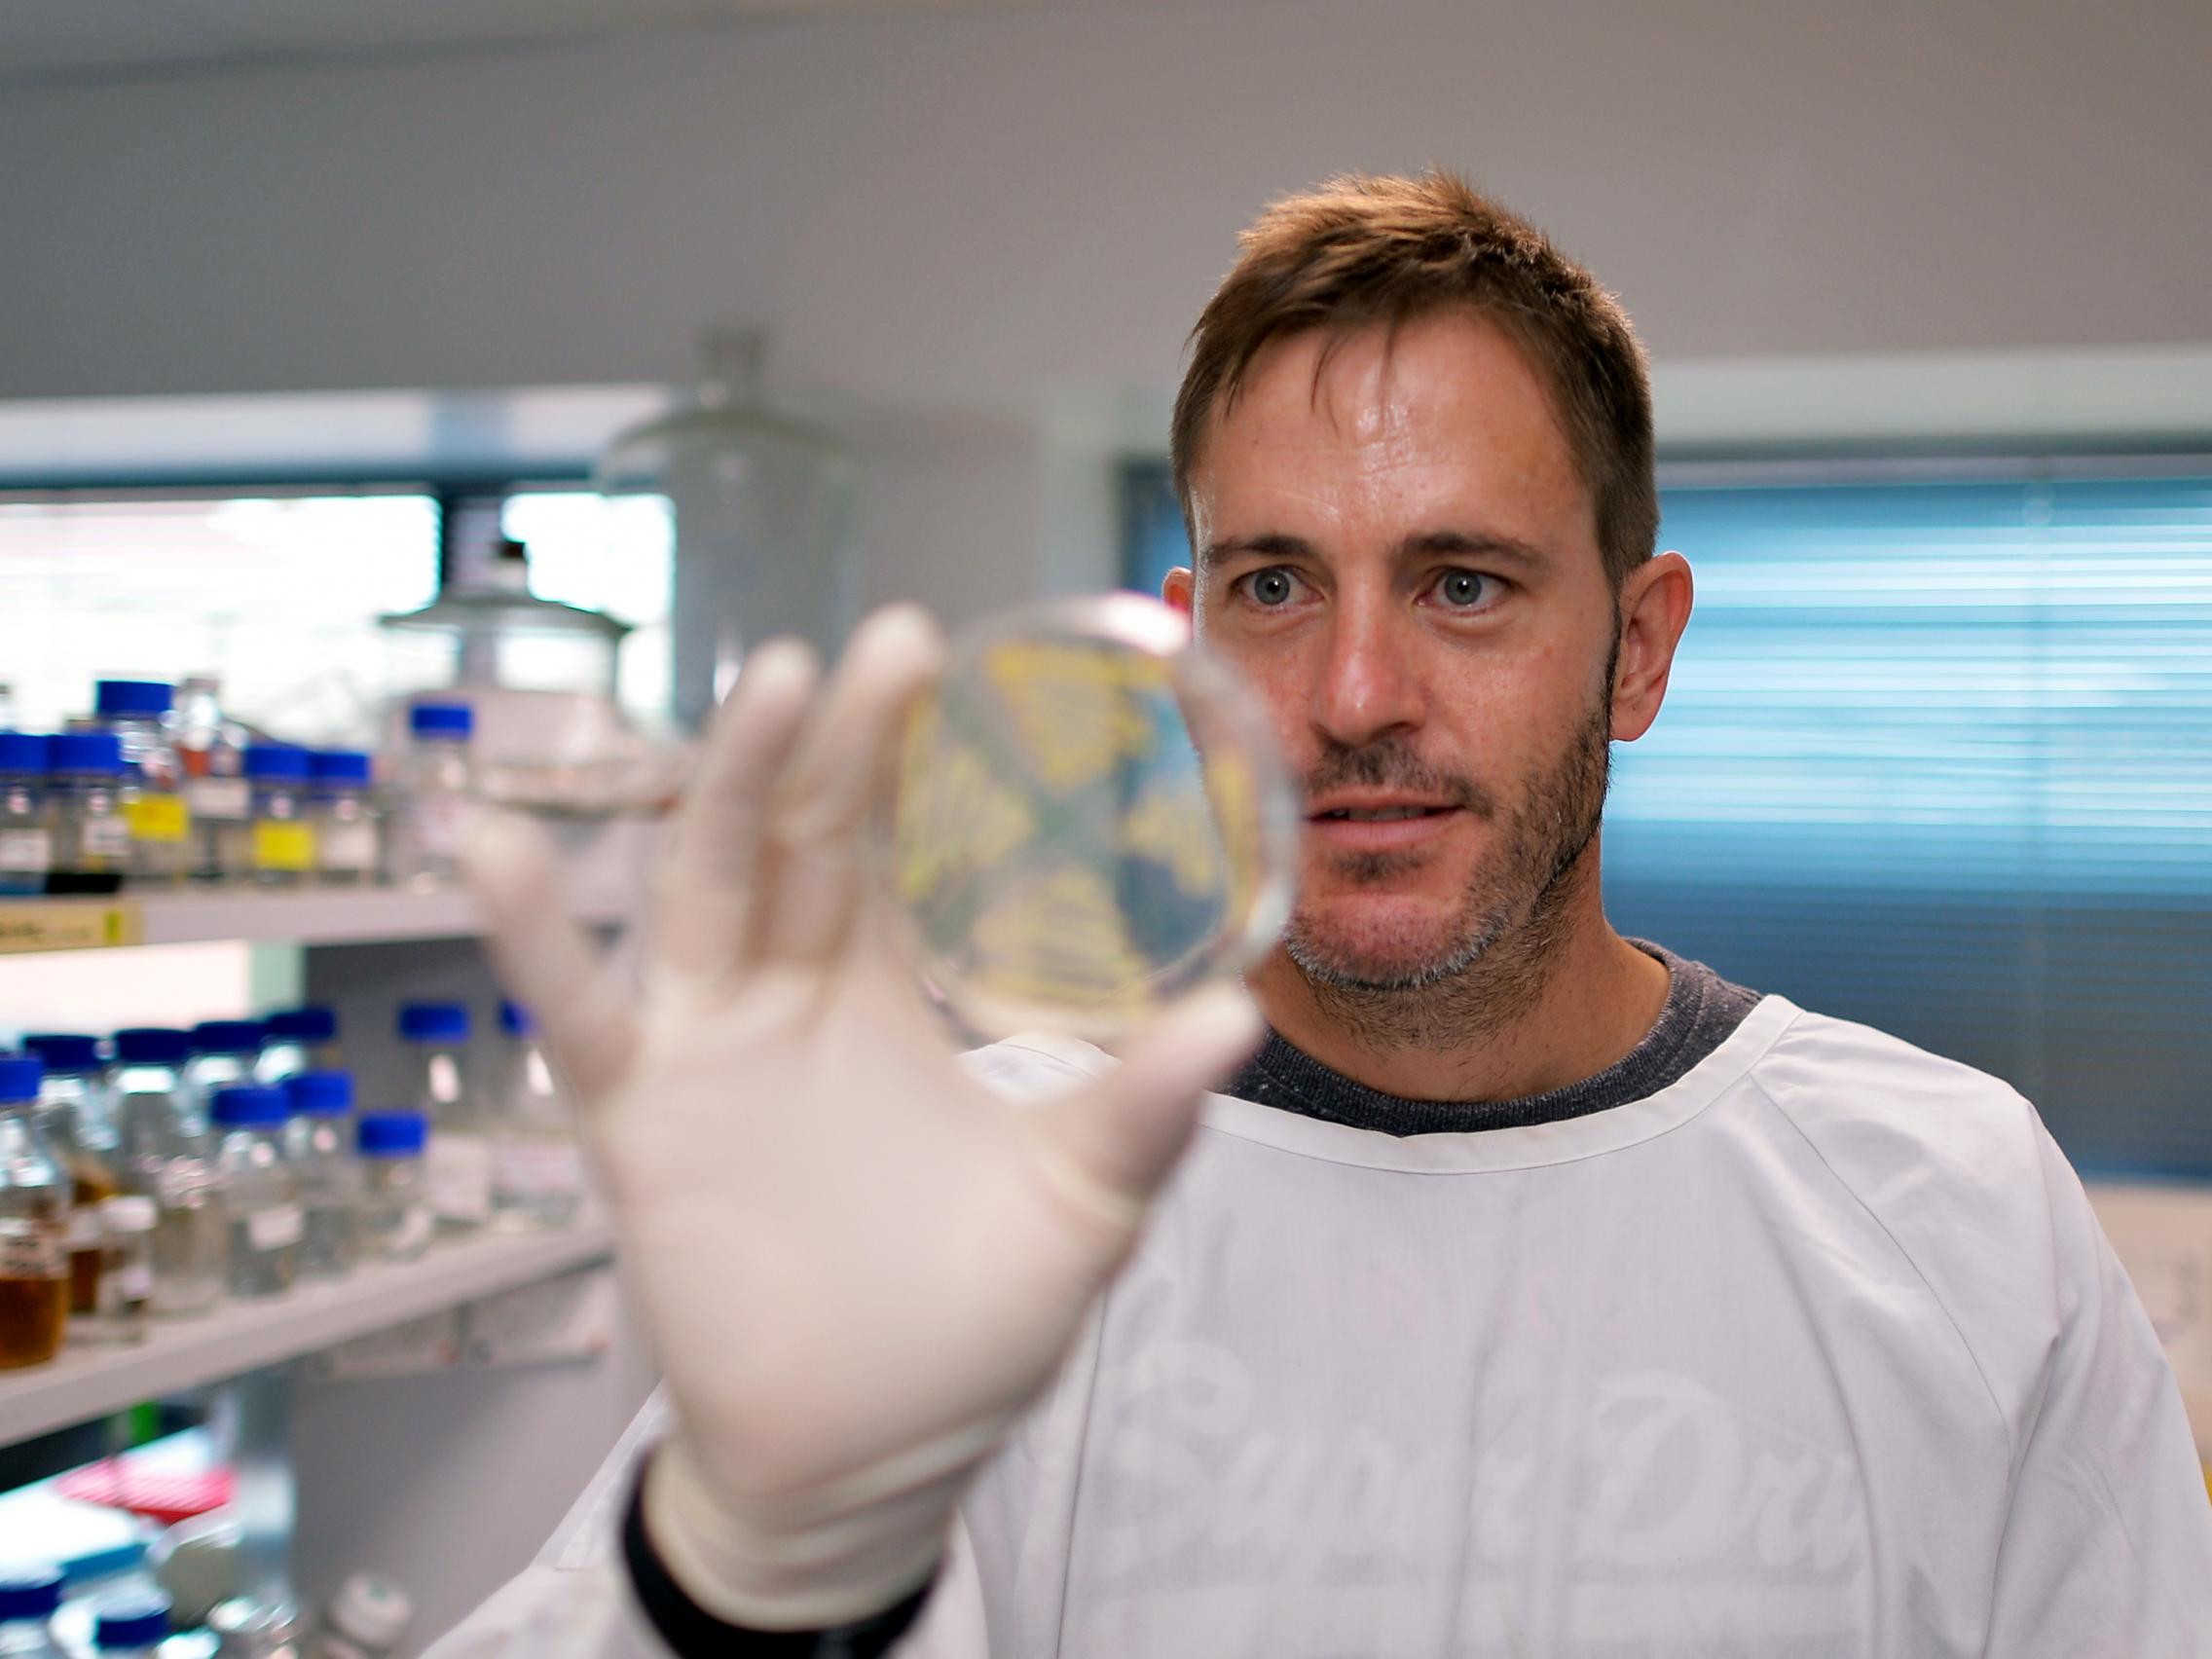
Dr Stephen Kidd

Group B Strep & oxidative stress
Pursue an honours project aimed at identifying the response of Group B Streptococcus to relevant reactive oxygen and reactive nitrogen species.
Study infectious diseases and antimicrobial resistance
All pathogenic bacteria need specialised mechanisms to adapt to the conditions in which they inhabit. For pathogenic bacteria this includes the changes from the environment, reservoir and the different anatomical niches they can inhabit.
Many of these conditions are nonoptimal and create a stress on the bacteria. In addition, many host cells generate reactive chemicals as an anti-microbial process.
The work in our lab aims to study the particular pathways important in the pathogenic bacterial adaptation and that are unique to a specific species.
We have projects on various pathogens. Our work generally is focussed on using molecular biology to understand the transcriptional and metabolic pathways that are important to the bacterial stress response.
Supervisor
Research area: Research Centre for Infectious Diseases (RCID) | Australian Centre for Antimicrobial Resistance Ecology (ACARE)
Recommended honours enrolment: Honours in Molecular and Biomedical Science
